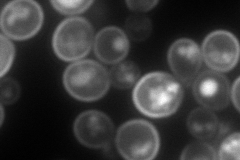
YOL158C
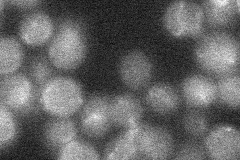
YOL158C
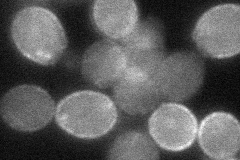
YOL158C
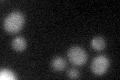
YOL158C

View description
Endosomal ferric enterobactin transporter, expressed under conditions of iron deprivation; member of the major facilitator superfamily; expression is regulated by Rcs1p and affected by chloroquine treatment
Localization:
Intensity:
Fold change:
Significance:
-
C’ GFP library in SD

below threshold15.99 -
N' NOP1pr-GFP in SD

cell periphery108.578 -
N' TEF2pr-mCherry in SD
cell periphery,vacuole150.042 -
N' NATIVEpr-GFP in SD
below threshold17.0718 -
N' TEF2pr-VC and Cyto-VN in SD
cell periphery46.0507 -
C’ GFP library in SD+DTT
cytosol14.680.91No -
C’ GFP library in SD+H2O2

cytosol16.221.01No -
C’ GFP library in Starvation Media

cytosol16.831.05No -
C’ GFP library on the background of Pup2-DaMP

below threshold -
C’ GFP library on the background of CCT mutant

below threshold14.60630.913297No
